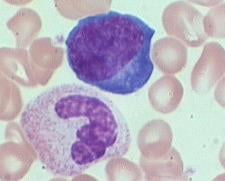

|
|
Εφημεριδάκι με online ενημέρωση για επαγγελματίες υγείας
ΣΥΓΧΡΟΝΗ ΙΑΤΡΙΚΗ ΓΙΑ ΕΙΔΙΚΟΥΣ ΚΑΙ ΜΗ |
||||
|
|
|||||
|
ΕΙΔΗΣΕΙΣ ΑΠΟ ΤΟ
ΧΩΡΟ ΤΗΣ ΥΓΕΙΑΣ ΙΑΤΡΙΚΑ
ΑΝΕΚΔΟΤΑ ΤΕΣΤ
ΑΥΤΟΑΞΙΟΛΟΓΗΣΗΣ ΔΙΑΔΙΚΤΥΑΚΟ
ΠΕΡΙΟΔΙΚΟ |
|
Λεμφοκυτταρικός τύπος Δρ Ουρ. Σπυράκου – Παπακωνσταντίνου Ιατρός Βιοπαθολόγος ΤΙ ΕΙΝΑΙ Ένα κοινό είδος λευκών αιμοσφαιρίων που ανευρίσκεται στη γενική εξέταση αίματος είναι τα λεμφοκύτταρα. Ενδεικτικά σε μια συνήθη απάντηση γενικής αίματος διαβάζουμε ότι στο αίμα μας 31% των λευκών αιμοσφαιρίων είναι λεμφοκύτταρα (ή 2325 λεμφοκύτταρα/μl αίματος). Είναι όμως όλα τα λεμφοκύτταρα ίδια; Σε μικροσκοπική εξέταση ένας έμπειρος εξεταστής μπορεί να διακρίνει έξη (6) και πλέον τύπους λεμφοκυττάρων και να διευκολύνει σημαντικά τη διάγνωση, κάτι που και οι πλέον σύγχρονοι αυτόματοι αιματολογικοί αναλυτές αδυνατούν να κάνουν: (1) Φυσιολογικά (ή ώριμα) λεμφοκύτταρα. (2) Αντιδραστικά λεμφοκύτταρα (reactive lymphocytes). Στο παρελθόν ονομάζονταν ανεπιτυχώς «κύτταρα ίωσης». Στα αντιδραστικά λεμφοκύτταρα κατατάσσονται και τα ειδικά για τη νόσο «κύτταρα κοκκύτη». (3) Κύτταρα Türk (ανοσοβλάστες). (4)
Πλασματοκύτταρα. (5)
Λεμφοβλάστες. (6)
Άλλοι τύποι λεμφοκυττάρων. Επομένως υπάρχουν δύο εντελώς διαφορετικές μέθοδοι εξέτασης των λεμφοκυττάρων αίματος: (α) Η ΜΑΖΙΚΗ του αυτόματου αιματολογικού αναλυτή δίνει ως αποτέλεσμα στο παράδειγμά μας λεμφοκύτταρα = 2325/μL, κάτι που σε γενικές γραμμές θεωρείται φυσιολογικό και (β)
Η ΛΕΠΤΟΜΕΡΗΣ (λεμφοκυτταρικός τύπος) από έμπειρο εξειδικευμένο εξεταστή, που
εξετάζοντας μικροσκοπικά το αίμα (του ίδιου ασθενή) απαντά: Αριθμός
λεμφοκυττάρων = 2325/μl, Τύπος λεμφοκυττάρων:
Ώριμα λεμφοκύτταρα = 68%, Κύτταρα Turk (ανοσοβλάστες)= 32%, απάντηση που
παραπέμπει σε σοβαρές παθολογικές καταστάσεις. (Φυσιολογικά τα ώριμα είναι
100%). ΠΟΥ
ΧΡΗΣΙΜΕΥΕΙ Με
την ανάλυση λεμφοκυτταρικού τύπου μπορεί να τεθεί η αρχική διάγνωση του
κοκκύτη (μιας δυσδιάγνωστης εργαστηριακά λοίμωξης), της οξείας λεμφοβλαστικής
λευχαιμίας, της λοιμώδους μονοπυρήνωσης, της νόσου Lyme και
πολλών άλλων νοσημάτων, ακόμα και όταν δεν έχουν εμφανή παθολογικά ευρήματα
στη γενική εξέταση αίματος. Τέλος, σύμφωνα με πρόσφατη
μελέτη Ελλήνων ερευνητών ο λεμφοκυτταρικός τύπος είναι εργαστηριακή εξέταση η
οποία διευκολύνει τη διάγνωση Long Covid.
Η εργασία αυτή (original paper) σύντομα θα αναρτηθεί στο ανανεωμένο
IDEA MEDICAL NEWSLETTER (https://www.idea-lab.gr/newsletter.htm). (Αναρτήθηκε: 17/11/2024)
Τριχόπτωση σε υγιείς γυναίκες Ο ρόλος των ιχνοστοιχείων Διονυσία Δήμα Πτυχιούχος Μαιευτικής -
Συνεργάτιδα IDEA Medical Labs ΛΙΓΑ ΛΟΓΙΑ ΓΙΑ ΤΗΝ ΤΡΙΧΟΦΥΪΑ Στο τριχωτό της κεφαλής υπάρχουν φυσιολογικά από 100.000 έως 300.000 τριχοθυλάκια από τα οποία προέρχονται οι τρίχες. Βέβαια πολλά από τα τριχοθυλάκια αυτά είναι αδρανή. Η ανάπτυξη των τριχών του κεφαλιού ακολουθεί κυκλική πορεία. Στην πρώτη φάση (αναγενής) η τρίχα αυξάνεται σε μήκος. Στο τέλος της αναγενούς φάσης ο ρυθμός αύξησης της τρίχας μειώνεται και στη βάση της τρίχας σχηματίζεται μια διόγκωση (καταγενής φάση). Τέλος η τρίχα πέφτει σε μια φάση ηρεμίας (τελογενής). Σε γενικές γραμμές η αναγενής φάση διαρκεί κατά μέσο όρο 1000 ημέρες (3 χρόνια), η καταγενής λίγες ημέρες και η τελογενής άλλες 100 περίπου ημέρες (3 μήνες). Πρέπει όμως να σημειωθεί ότι η διάρκεια αυτών των φάσεων είναι διαφορετική σε κάθε άτομο και εξαρτάται τόσο από γενετικούς παράγοντες όσο και από την επάρκεια του οργανισμού σε ορισμένα θρεπτικά συστατικά, βιταμίνες και ιχνοστοιχεία. Φυσιολογικά κάθε στιγμή 10-15% των τριχών της κεφαλής βρίσκονται σε τελογενή φάση. Φυσιολογικά 50-150 τρίχες αποπίπτουν κάθε μέρα, επειδή όμως άλλες τόσες περίπου αναπαράγονται δεν παρατηρούνται διαφορές στην πυκνότητα των τριχών. Όταν οι τρίχες που πέφτουν είναι περισσότερες από αυτές που παράγονται μιλάμε για αλωπεκία ή τριχόπτωση. Υπάρχουν διάφορα παθολογικά αίτια που ενοχοποιούνται για την τριχόπτωση στις γυναίκες: (1) Ορμονικές διαταραχές από δυσλειτουργία των ωοθηκών, του θυρεοειδούς κλπ. (2) Γενετικοί - ενδοκρινικοί παράγοντες (ανδρογενετική αλωπεκία). (3) Λοιμώδη νοσήματα (π.χ. σύφιλη, μυκητίαση, Covid-19). (4) Επίδραση φυσικών παραγόντων (π.χ. εγκαύματα από θερμότητα ή ακτινοβολία) (5) Λήψη ορισμένων φαρμάκων (π.χ. κυτταροστατικά, αντιπηκτικά). (6) Αυτοάνοσα νοσήματα (π.χ. δερματικός ερυθηματώδης λύκος, γυροειδής αλωπεκία). Όλες αυτές συνολικά οι παθολογικές καταστάσεις ενοχοποιούνται για λιγότερο από 5% των περιπτώσεων αυξημένης τριχόπτωσης στις γυναίκες Αντίθετα το 95% των γυναικών που παραπονούνται για τριχόπτωση είναι άτομα, φαινομενικά τουλάχιστον, υγιή που δεν πάσχουν από κάποιο καθορισμένο νόσημα. ΑΛΗΘΕΙΕΣ & ΜΥΘΟΙ ΓΙΑ ΤΗΝ ΤΡΙΧΟΠΤΩΣΗ Αντίθετα με τους άνδρες στους οποίους το φαινόμενο θεωρείται φυσιολογικό, η αραίωση του τριχωτού της κεφαλής των γυναικών δεν είναι αισθητικά αποδεκτή στις δυτικές κοινωνίες. Έτσι δημιουργήθηκαν διάφορες προλήψεις, που συχνά δεν ανταποκρίνονται στην πραγματικότητα, αλλά και διάφοροι επιχειρηματίες βρήκαν την ευκαιρία να κερδοσκοπήσουν «θεραπεύοντας» αυτή την κατάσταση. Πριν προχωρήσουμε θεωρείται σκόπιμο να αναφερθούμε με λίγα λόγια στις συχνότερες από τις δοξασίες που κυκλοφορούν με βάση τα υπάρχοντα επιστημονικά δεδομένα. Η πιο συχνή αιτία τριχόπτωσης στις γυναίκες είναι η
κληρονομικότητα; Αντίθετα με τους άνδρες στους οποίους πράγματι η συχνότερη αιτία για την εμφάνιση αλωπεκίας (φαλάκρα) είναι η κληρονομικότητα, στις γυναίκες ο παράγοντας αυτός δεν φαίνεται να είναι σημαντικός. Κι αυτό γιατί η ορμονική σύσταση του οργανισμού της προστατεύει τη γυναίκα από τις επιδράσεις των κληρονομικών παραγόντων. Τριχόπτωση (συνήθως πρόσκαιρη) παρατηρείται όταν η ορμονική ισορροπία διαταράσσεται π.χ. κατά την εμμηνόπαυση, την εγκυμοσύνη ή τη λήψη ορμονικών σκευασμάτων. Σε παθολογικές καταστάσεις που στον οργανισμό της γυναίκας κυκλοφορούν αυξημένα ποσά ανδρογόνων ορμονών τότε είναι δυνατόν να ενεργοποιηθούν οι κληρονομικοί παράγοντες και να εμφανιστεί η παθολογική κατάσταση που ονομάζεται ανδρογενετική αλωπεκία. Η αυξημένη τριχόπτωση μετά την εγκυμοσύνη οφείλεται σε
ορμονικούς παράγοντες; Ίσως σε ένα πολύ μικρό ποσοστό. Όμως ο κύριος λόγος τριχόπτωσης μετά τον τοκετό είναι το γεγονός ότι το έμβρυο απορρόφησε κατά τη διάρκεια της εγκυμοσύνης από τον οργανισμό της μητέρας για τις δικές του ανάγκες ένα σημαντικό ποσοστό από τα αποθέματα θρεπτικών ουσιών, βιταμινών και ιχνοστοιχείων. Το στρες μπορεί να προκαλέσει τριχόπτωση; Είναι αλήθεια πως η έντονη ψυχική ή και σωματική καταπόνηση (stress) προκαλεί παροδική συνήθως απώλεια τριχών. Ο μηχανισμός είναι κυρίως ορμονικός με έκκριση ορισμένων ορμονών των επινεφριδίων (αδρεναλίνη, κορτιζόλη) οι οποίες επιδρούν στα τριχοθυλάκια. H Covid-19
προκαλεί τριχόπτωση; Η τριχόπτωση είναι όψιμη επιπλοκή αυτής της λοίμωξης. Τα μαλλιά συνήθως πέφτουν από τη 2η έως την 8η εβδομάδα από τη νόσηση. Εκτός από τη νόσο, τριχόπτωση προκαλούν και κάποια συμπληρώματα ψευδαργύρου που λαμβάνουν γυναίκες για τη θεραπεία της Covid-19 και έτσι προκαλείται περίσσεια ψευδαργύρου (βλ. παρακάτω ΙΧΝΟΣΤΟΙΧΕΙΑ ΚΑΙ ΤΡΙΧΟΠΤΩΣΗ) Η περιποίηση των μαλλιών στο κομμωτήριο (hair styling) προκαλεί
τριχόπτωση; Ίσως ορισμένοι τύποι χτενίσματος όπως οι πολύ σφικτοί κότσοι ή η αλογοουρά μπορούν να προκαλέσουν τριχόπτωση, η οποία οφείλεται στην αυξημένη τάση. Η χρήση λακ, ζελέ ή βαφών μπορεί επίσης να προκαλέσει τριχόπτωση. Αυτά τα χημικά παρασκευάσματα προκαλούν βλάβη στο στέλεχος της τρίχας. Όμως σε όλες αυτές τις περιπτώσεις τα τριχοθυλάκια, που βρίσκονται κάτω από την επιδερμίδα μένουν ανέπαφα. Το πιστολάκι είναι «αποτεφρωτήρας τριχοθυλακίων»; Δεν υπάρχει καμιά πειστική απόδειξη πως ο στεγνωτήρας μαλλιών (πιστολάκι) ευνοεί την τριχόπτωση ή λεπταίνει τις τρίχες. Ωστόσο καλό είναι να μη ρυθμίζεται πολύ υψηλά η θερμοκρασία και να διατηρείται κάποια απόσταση κατά το στέγνωμα. Η κοπή των μαλλιών τα «δυναμώνει»; Ευσεβής πόθος. Η ανάπτυξη των μαλλιών (και το μήκος τους) εξαρτάται από τη διάρκεια της αναγενούς φάσης που όπως είπαμε είναι μοναδική σε κάθε άνθρωπο και εξαρτάται τόσο από κληρονομικούς παράγοντες όσο και από την περιεκτικότητα σε ορισμένα θρεπτικά συστατικά, βιταμίνες και ιχνοστοιχεία. Το βούρτσισμα και το μασάζ «δυναμώνουν» τα μαλλιά; Υπάρχει ένας μύθος πως αν κάποια γυναίκα βουρτσίζει τα μαλλιά της 100 φορές την ημέρα, αυτά θα δυναμώσουν γιατί βελτιώνεται η κυκλοφορία του αίματος στο δέρμα. Το ίδιο υποτίθεται πως κάνει η μάλαξη (massage) του τριχωτού δέρματος. Η επιστημονική αλήθεια είναι πως δεν υπάρχει καμιά διαφορά στην αιμάτωση του δέρματος του κεφαλιού είτε είναι φαλακρό είτε σκεπάζεται από πυκνό τρίχωμα. Ειδικά συμπληρώματα ή φόρμουλες βιταμινών, αμινοξέων και ιχνοστοιχείων ελαττώνουν την τριχόπτωση; Πολύ συχνά η έλλειψη αλλά και η περίσσεια κάποιου θρεπτικού συστατικού μπορεί να προκαλέσει άλλοτε άλλου βαθμού τριχόπτωση. Ακραίες στερητικές καταστάσεις είναι σπάνιες στις δυτικές κοινωνίες και παρατηρούνται μόνο μετά την εγκυμοσύνη ή σε ομάδες με ειδικές διατροφικές συνήθειες όπως οι αυστηρά χορτοφάγοι (vegans). Η χορήγηση συμπληρωμάτων διατροφής σταθερής σύστασης (ενδεικτικά: Priorin, Aminactif) μπορεί μερικές φορές να βελτιώσει την κατάσταση. Αν όμως από τον οργανισμό λείπει κάποιο στοιχείο που δεν περιέχεται στη σύνθεση του σκευάσματος τότε η τριχόπτωση θα συνεχιστεί ή και θα επιδεινωθεί. Πολύ χειρότερα θα είναι τα πράγματα αν στον οργανισμό υπάρχει περίσσεια κάποιου στοιχείου που περιέχεται στο σκεύασμα. Στην τελευταία περίπτωση οι συνέπειες από τη χορήγηση του σκευάσματος είναι απρόβλεπτες, αφού το συστατικό αυτό ενδέχεται να αυξηθεί σε τοξικά επίπεδα. Η πιο γνωστή περίπτωση τοξικής επίδρασης διατροφικού συμπληρώματος είναι η υπερβιταμίνωση Α, που προκαλεί μόνιμη και μη αναστρέψιμη αλωπεκία (φαλάκρα). ΙΧΝΟΣΤΟΙΧΕΙΑ ΚΑΙ ΤΡΙΧΟΠΤΩΣΗ ΣΤΙΣ ΓΥΝΑΙΚΕΣ Στη βιολογία ιχνοστοιχεία ή ολιγοστοιχεία (trace elements ή oligoelements) ονομάζονται ανόργανες ουσίες που σε πολύ μικρές ποσότητες είναι απαραίτητες για τη φυσιολογική λειτουργία του οργανισμού. Τα συστατικά αυτά είναι συνήθως μέταλλα, τα οποία πρέπει να τα προσλάβει ο οργανισμός με τις τροφές γιατί δεν μπορεί να τα συνθέσει μόνος του. Απαραίτητες για τον οργανισμό σε μικροποσότητες είναι και ουσίες οργανικής προέλευσης, οι βιταμίνες. Τα ιχνοστοιχεία αποτελούν συστατικά και των τριχών. Μάλιστα σε ορισμένα εργαστήρια του εξωτερικού προσδιορίζονται τα ιχνοστοιχεία σε δείγματα τριχών. Η μέθοδος όμως αυτή δεν είναι ιδιαίτερα αξιόπιστη γιατί προσμετρώνται και ιχνοστοιχεία προερχόμενα από επιμόλυνση των τριχών λόγω της ατμοσφαιρικής ρύπανσης και υπολείμματα από σαμπουάν, βαφές κλπ. Σίδηρος: Η επιστημονική έρευνα έχει δείξει πως η έλλειψη σιδήρου είναι συχνή αιτία τριχόπτωσης σε γυναίκες. Η έλλειψη αυτού του μετάλλου μπορεί να συνοδεύεται από αναιμία, αλλά υπάρχουν πολλά περιστατικά τριχόπτωσης στα οποία η τιμή της αιμοσφαιρίνης είναι φυσιολογική. Στις περισσότερες περιπτώσεις σιδηροπενίας ανευρίσκονται μειωμένα τόσο ο σίδηρος στον ορό του αίματος όσο και η φερριτίνη που αντιπροσωπεύει τα αποθέματα σιδήρου. Καλύτερη μέθοδος προσδιορισμού του σιδήρου είναι η ατομική απορρόφηση, η οποία όμως δεν χρησιμοποιείται συχνά λόγω του ότι απαιτεί ακριβό εξοπλισμό και εξειδικευμένο προσωπικό. Η διόρθωση του επιπέδων σιδήρου επιφέρει βραδεία βελτίωση της τριχόπτωσης. Συνήθως απαιτούνται 2-3 μήνες για να ελαττωθεί η τριχόπτωση και άλλους 3-6 μήνες για να αποκτήσουν οι νέες τρίχες ικανοποιητικό μήκος, ώστε να αυξηθεί ο όγκος των μαλλιών. Θα πρέπει να σημειωθεί ότι και η περίσσεια σιδήρου στον οργανισμό προκαλεί τριχόπτωση και υπέρχρωση του δέρματος εκτός από τις βλάβες που προκαλεί στα εσωτερικά όργανα (αιμοσιδήρωση). Πυρίτιο: Το πυρίτιο είναι απαραίτητο για τη φυσιολογική ανάπτυξη των τριχών. Έρευνες που έχουν γίνει στην πρώην Σοβιετική Ένωση, αλλά και στα Ιατρικά Διαγνωστικά Εργαστήρια, δείχνουν πως η έλλειψη πυριτίου προκαλεί τριχόπτωση. Στη θεραπευτική χρησιμοποιείται το διοξείδιο του πυριτίου (Silica). Ορισμένα σαμπουάν περιέχουν silica, όμως δεν είναι ως σήμερα γνωστό αν η τοπική εφαρμογή έχει αποτελέσματα. Ψευδάργυρος: Σύμφωνα με τις πλέον πρόσφατες επιστημονικές έρευνες η έλλειψη ψευδαργύρου (Zinc) αυξάνει την έκκριση μιας ουσίας που λέγεται παράγοντας νέκρωσης των όγκων (TNF-α) η οποία ερεθίζει το ανοσοποιητικό σύστημα ώστε να καταστρέφει τους ιστούς του σώματος περιλαμβανομένων και των τριχών. Αυτός είναι ο μηχανισμός με τον οποίο η έλλειψη ψευδαργύρου προκαλεί τριχόπτωση στις γυναίκες. Αλλά και η περίσσεια ψευδαργύρου, όπως και η χορήγηση υψηλών δόσεων συμπληρωμάτων προκαλεί επιβράδυνση της αύξησης του μήκους των τριχών με άμεση επίδραση στην αναγενή φάση. Σελήνιο: Το ισχυρό αντιοξειδωτικό σελήνιο βοηθά τον οργανισμό να χρησιμοποιήσει τις διάφορες πρωτεΐνες που καταναλώνει και οι τρίχες αποτελούνται από πρωτεΐνες κατά κύριο λόγο. Αυτός φαίνεται πως είναι ο κύριος μηχανισμός με τον οποίο η έλλειψη σεληνίου προκαλεί τριχόπτωση. Σε κάθε περίπτωση το σελήνιο σε υψηλές συγκεντρώσεις είναι τοξικό. Μολυβδαίνιο: Σε υψηλές συγκεντρώσεις το μολυβδαίνιο προκαλεί μεταξύ των άλλων τριχόπτωση. Το μολυβδαίνιο αίματος στην Ελλάδα προσδιορίστηκε για πρώτη φορά και καθορίστηκαν οι φυσιολογικές τιμές αίματος στα Ιατρικά Διαγνωστικά Εργαστήρια IDEA Medical Labs το 2004 (https://www.idea-lab.gr/newslet20090307.htm) Χαλκός: Η έλλειψη χαλκού προκαλεί μεταξύ των άλλων τριχόπτωση και πρόωρο αποχρωματισμό (λεύκανση) των μαλλιών. Χρώμιο: Υπάρχουν αρκετές έρευνες που δείχνουν πως η περίσσεια χρωμίου εκδηλώνεται με τριχόπτωση στις γυναίκες. Μαγγάνιο: Η έλλειψη μαγγανίου προκαλεί επιβράδυνση της αναγενούς φάσης των τριχών και η λήψη συμπληρωμάτων μαγγανίου διορθώνει αυτή την κατάσταση. Τα συμπληρώματα μαγγανίου εξάλλου ελαττώνουν την τριχόπτωση που προκαλείται από περίσσεια ψευδαργύρου (όταν φυσικά δεν υπάρχει περίσσεια μαγγανίου). Ρουβίδιο: Το ρουβίδιο είναι ένα σπάνιο στη φύση ιχνοστοιχείο η σχετική έλλειψη του οποίου εκδηλώνεται και με τριχόπτωση. Η έλλειψη του ιχνοστοιχείου σ’ αυτή την περίπτωση εκδηλώνεται έμμεσα και συγκεκριμένα προκαλεί ορμονικές διαταραχές από δυσλειτουργία της υπόφυσης. Μόλυβδος, Κάδμιο, Αργίλιο (Αλουμίνιο): Αυτά τα μέταλλα είναι εξαιρετικά τοξικά κυρίως για το νευρικό σύστημα και η τιμή τους στο αίμα δεν πρέπει ποτέ να υπερβαίνει ορισμένα όρια. Σε τοξικά επίπεδα όπως είναι αναμενόμενο προκαλούν και τριχόπτωση, αλλά αυτό είναι το μικρότερο κακό. Άλλα ιχνοστοιχεία: Άλλα σημαντικά ιχνοστοιχεία που ο προσδιορισμός τους έχει αξία είναι το βανάδιο, το ιώδιο, το κοβάλτιο, το νικέλιο κ.ά. Τα σημαντικότερα ιχνοστοιχεία προσδιορίζονται στο αίμα από το συνεργαζόμενο εργαστήριο Proteomis (Βρυξέλλες) με μέθοδο ατομικής απορρόφησης (GF-AAS) και σχεδιάζεται ένα διάγραμμα με τις ελλείψεις και τις περίσσειες σε καθένα. Στη συνέχεια ακολουθείται ειδική θεραπεία αποκατάστασης της ισορροπίας με αποτέλεσμα τη διακοπή της τριχόπτωσης και την αποκατάσταση του τριχωτού της κεφαλής. (Ενημερώθηκε: 17/11/2024) |
|||